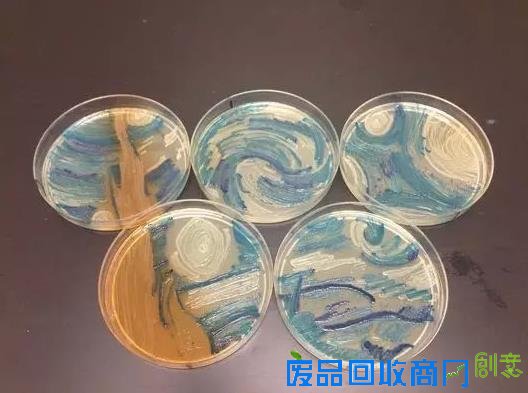
《星夜》再现：科学家利用DNA折纸术复活梵高名作

细菌版《星夜》
这项技术被称为“DNA折纸术”。此前已有科学家利用这项技术创造了多种不同形状的作品,但《星夜》是科学家第一次成功证明可在计算机芯片上扩展并构建大量DNA装置。加州理工学院团队在《自然》杂志上发表的文章中详细描述了这一研究成果。
“每人都认同分子终将构成未来的设备装置,”加州理工学院DNA折纸术创始者及论文共同作者保罗·罗斯蒙德说道。“然而如何将它们连接起来?怎样把它们串连成回路?又该如何对它们加以利用?分子与宏观世界之间需要一个接口,而这正是我们所研究的东西。”
从罗斯蒙德出于好玩做出的第一个折叠DNA组到现在,已过去了十年。2008年,他创作的纳米级笑脸、星星、雪花和一幅微缩西半球地图甚至被放在纽约现代艺术博物馆里展出。科学与艺术的联姻莫过于此。

罗斯蒙德团队创作出的DNA折纸笑脸
DNA具有双螺旋结构,包含了制造蛋白质所需的一切遗传指令。它有四种碱基,被称为A、T、G和C。A总是与T配对,G总是与C配对。
为了创造出特定的形状,罗斯蒙德将一条DNA长链反复折叠成自己想要的任意形状或图案(事先以计算机建模设计好的),然后在关键位置用DNA短链构成的“图钉”将其衔接起来。每个V型图钉都通过碱基序列组成的两条“手臂”与DNA长链上的互补序列“钉”在一起。随后,罗斯蒙德将DNA长链在盐溶液中加热,令其自行组装成想要的图案。
在计算机上设计图案需要花大约一周时间,接下来合成DNA也要一周左右,而实际的自组装只需数小时。“然而你面对的就是在溶液中漂浮的孤立装置,无法与其他任何东西相连,无法接入回路,甚至连测量其性能都非常困难。”

一长串DNA折纸笑脸
罗斯蒙德明白,如果想要投入实际应用,他就必须想办法将他的DNA折纸与硅微加工整合在一起。2009年,他与IBM的科学家们联手在芯片上添置了和DNA折纸大小及形状一模一样的黏片。只要将含有DNA的溶液倾倒在芯片上,DNA分子就会附着在这些黏片上。这样得来的DNA形状就发挥了“脚手架”的作用,可以与诸如荧光分子之类的其他小部件连接在一起。
自此,罗斯蒙德与他的同事们便一直致力于改良这项技术。在过去的6年间,他与加州理工学院博士后艾什温·戈皮纳特一起证明了他们可以将DNA折纸置于几乎所有制作计算机芯片的表面。他们在最新的论文中谈及了初次应用:利用这种方法将荧光分子粘连成微型光源,一如将灯泡旋入灯座。这些实验中的“灯”就是调整至特定光波长的光子晶体微腔,在《星光》中呈现出一种深红色。
![]()
DNA折纸作品《星夜》
注入的荧光分子按照特定波长发光,于是便“点亮”了“灯”。但位置才是关键:光子晶体微腔中某些位置的分子比其他位置的分子发出的光更亮。这就赋予了科学家们更大的自由来进行更多的创作。出于对梵高的热爱,戈皮纳特选择了《星夜》来展现DNA折纸术的强大威力。除此之外,他的灵感还来源于《神秘博士》系列剧集中的《文森特与博士》。在这一集中,万人迷的时间领主回到1890年,与虚构的梵高一起击退了进犯的外星怪兽。先前的作品往往只用到数个“灯”,而这一次,戈皮纳特大手笔地动用了共65536个这样的装置,以求忠实复原梵高的旷世杰作。
物理学家则更希望发掘DNA折纸术的潜力,将其用于基础实验。例如,在接下来的一系列实验中,多个发射器将被放置于谐振器中,并使它们彼此同步。这一首次由罗伯特·狄克在1952年所预言的现象叫作“超辐射”。
![]()
梵高的原作《星夜》
戈皮纳特将这种效应比喻为在桌上放置一排原本并不同步的节拍器,只要条件允许,便会随时间推移逐渐节拍一致。同样地,多个光发射器也会最终同步。“目前尚无人能完成这一实验,因为必须将发射器按照彼此间特定的距离摆放。”戈皮纳特称。他们的新论文无疑为这一实验提供了一种新的可能。
[广告]投资优惠入口:
买美股,上老虎 - 超低佣金,每股只需1美分